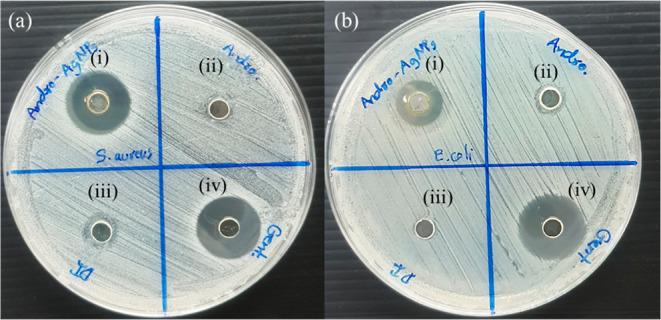
https://cdn.ncbi.nlm.nih.gov/pmc/blobs/b141/10633854/b593591f94d5/ao3c03789_0008.jpg

穿心莲内酯稳定的银纳米颗粒对水中汞(II)离子的高选择性比色传感器及抗菌评估
Highly Selective Colorimetric Sensor of Mercury(II) Ions by Andrographolide-Stabilized Silver Nanoparticles in Water and Antibacterial Evaluation.
作者信息
Talodthaisong Chanon, Sangiamkittikul Pitiphoom, Chongwichai Panupong, Saenchoopa Apichart, Thammawithan Saengrawee, Patramanon Rina, Kosolwattana Suppanat, Kulchat Sirinan
机构信息
Department of Chemistry, Faculty of Science, Khon Kaen University, Khon Kaen 40002, Thailand.
Materials Chemistry Research Center, Department of Chemistry and Center of Excellence for Innovation in Chemistry, Faculty of Science, Khon Kaen University, Khon Kaen 40002, Thailand.
出版信息
ACS Omega. 2023 Oct 23;8(44):41134-41144. doi: 10.1021/acsomega.3c03789. eCollection 2023 Nov 7.
Silver nanoparticles (AgNPs) are well known for their exceptional properties and versatility in various applications. This study used andrographolide as a biochemical stabilizer to synthesize AgNPs (andro-AgNPs). The andro-AgNPs were characterized by using UV-vis spectroscopy, revealing a surface plasmon resonance peak at 440 nm. Fourier transform infrared spectroscopy was also used to confirm the presence of AgNPs. Transmission electron microscopy was used to investigate the morphology of andro-AgNPs, which showed a spherical shape with an average diameter of 18.30 ± 5.57 nm ( = 205). Andro-AgNPs were utilized as a colorimetric sensor to detect mercury ions (Hg) in water, and the optimized detection conditions were evaluated using UV-vis spectroscopy with a linear range of 15-120 μM. The limit of detection and the limit of quantification for Hg detection were found to be 11.15 and 37.15 μM, respectively. Furthermore, andro-AgNPs exhibited antibacterial properties against both Gram-positive () and Gram-negative () bacteria. The results imply that andro-AgNPs hold promising potential for future biomedical applications.
银纳米颗粒(AgNPs)因其卓越的性能和在各种应用中的多功能性而闻名。本研究使用穿心莲内酯作为生化稳定剂来合成AgNPs(穿心莲内酯-AgNPs)。通过紫外可见光谱对穿心莲内酯-AgNPs进行表征,发现在440nm处有一个表面等离子体共振峰。傅里叶变换红外光谱也用于确认AgNPs的存在。透射电子显微镜用于研究穿心莲内酯-AgNPs的形态,其呈现出球形,平均直径为18.30±5.57nm(n = 205)。穿心莲内酯-AgNPs被用作比色传感器来检测水中的汞离子(Hg),并使用紫外可见光谱评估优化后的检测条件,线性范围为15 - 120μM。发现Hg检测的检测限和定量限分别为11.15和37.15μM。此外,穿心莲内酯-AgNPs对革兰氏阳性()和革兰氏阴性()细菌均表现出抗菌特性。结果表明穿心莲内酯-AgNPs在未来生物医学应用中具有广阔的潜力。